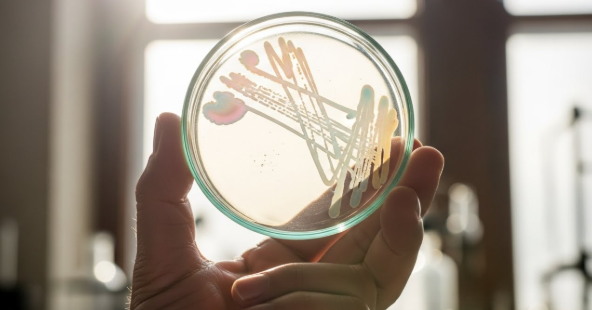
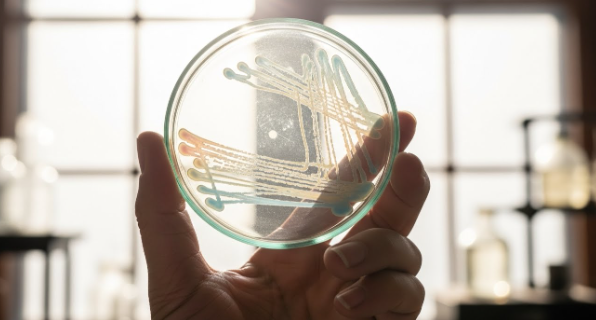

2025년 12월 15일, 코스닥 시장에서 가장 뜨거운 관심을 받은 종목 중 하나가 바로 에임드바이오였어요.
하루 만에 무려 26% 넘게 급등하며 투자자들의 시선을 단숨에 사로잡았거든요.
많은 분이 갑작스러운 상승세에 놀라기도 하고, 지금 진입해도 될지 고민하고 계실 텐데요.
도대체 어떤 기술력을 가졌길래 적자 기업임에도 불구하고 시가총액 4조 5천억 원을 넘어섰는지 궁금해하실 것 같아요.
오늘은 에임드바이오가 가진 핵심 기술인 ADC의 개념부터 향후 주가 전망까지 아주 쉽게 풀어서 설명해 드릴게요.



폭발적인 주가 상승, 시장은 무엇에 반응했나
에임드바이오의 주가는 12월 15일 종가 기준으로 70,500원을 기록했어요.
전일 대비 14,600원이 오르며 26.12%라는 놀라운 상승 폭을 보여주었죠.
거래량 또한 전일 대비 100% 이상 폭증하며 시장의 주도주 역할을 톡톡히 해냈는데요.
단순히 하루 반짝인 것이 아니라, 최근 바이오 섹터의 수급이 몰리며 '코스닥의 다크호스'로 급부상하고 있다는 점에 주목해야 해요.
시가총액은 어느새 4조 5,230억 원을 기록하며 코스닥 시총 순위 13위까지 치고 올라왔거든요.
외국인 지분율은 1.45%로 아직 낮은 편이지만, 기관과 개인 투자자들의 매수세가 거세게 유입되고 있는 상황이에요.
숫자로 보는 현재 위치
- 현재 주가: 70,500원 (2025년 12월 15일 기준)
- 등락률: 전일 대비 +26.12% 상승
- 시가총액: 약 4조 5,230억 원 (코스닥 13위)
- 52주 최고가: 72,600원 (신고가 갱신 흐름)



핵심 기술 분석: ADC가 도대체 뭐길래?
에임드바이오를 이해하려면 가장 먼저 'ADC(Antibody-Drug Conjugate)'라는 기술을 알아야 해요.
이 용어가 어렵게 느껴질 수 있지만, 비유하자면 '유도미사일'과 같다고 보시면 돼요.
기존의 항암제는 암세포뿐만 아니라 정상 세포까지 공격해서 부작용이 심했거든요.
하지만 ADC 기술은 항체(미사일)에 약물(폭탄)을 붙여서 암세포만 정확하게 타격하는 기술이에요.
에임드바이오는 바로 이 ADC 기반의 항암제를 개발하고 기술을 이전하는 것을 주력 사업으로 삼고 있어요.
차별화된 경쟁력: 환자 유래 모델 (PDC/PDX)
다른 ADC 개발사들과 에임드바이오가 다른 점은 바로 '환자 유래 모델'을 활용한다는 점이에요.
이게 무슨 뜻인지 조금 더 자세히 설명해 드릴게요.
- PDC (Patient-Derived Cells): 실제 환자의 암세포를 추출해 배양한 세포 모델이에요.
- PDX (Patient-Derived Xenograft): 환자의 암 조직을 쥐와 같은 실험동물에 이식해 만든 모델이에요.
이 모델들을 활용하면 실제 환자에게 약물을 투여했을 때와 가장 유사한 결과를 미리 예측할 수 있거든요.
즉, 임상 시험에서의 성공 확률을 비약적으로 높일 수 있다는 것이 이 회사의 가장 큰 무기예요.
자체 보유한 링커-페이로드 기술(폭탄을 미사일에 단단히 고정하고, 목표지점에서 정확히 터지게 하는 기술) 또한 글로벌 수준이라는 평가를 받고 있어요.

재무제표 분석: 적자 기업에 투자해도 될까?
재무제표만 놓고 보면 고개를 갸웃거리는 분들도 많으실 거예요.
2025년 3분기 기준으로 매출액은 미미하고, 영업이익은 약 -59억 원으로 적자를 지속하고 있거든요.
당기순이익 역시 -52억 원을 기록하며, 숫자로만 보면 위험해 보일 수 있어요.
ROE(자기자본이익률)도 마이너스를 기록하고 있어 전형적인 기술 특례 상장 바이오 기업의 모습을 보여주고 있죠.
바이오 기업 투자의 특수성
하지만 바이오 기업은 당장의 실적보다 '미래 가치'를 먹고 자라는 특성이 있어요.
현재의 적자는 신약 개발을 위한 R&D(연구개발) 투자 비용으로 해석해야 하거든요.
에임드바이오와 같은 섹터에 있는 알테오젠이나 리가켐바이오도 과거에는 적자였지만, 기술 수출 대박을 터뜨리며 주가가 급등했던 사례가 있어요.
투자자들은 지금의 적자가 아니라, 향후 글로벌 제약사로의 '기술 이전(License Out)' 가능성에 베팅하고 있는 셈이에요.
물론 부채비율이나 자금 조달 이슈는 투자 시 항상 체크해야 할 리스크 요인임은 분명해요.



2025년 시장 트렌드와 경쟁 현황
2025년 바이오 시장의 키워드는 단연코 ADC와 비만 치료제, 그리고 AI 신약 개발이에요.
에임드바이오는 이 중 가장 핫한 ADC 분야에 속해 있어 시장의 관심을 한 몸에 받고 있는 건데요.
동일 섹터의 대장주인 알테오젠이 시가총액 23조 원을 넘기며 굳건히 버티고 있고, 리가켐바이오 또한 탄탄한 흐름을 보여주고 있어요.
이는 바이오 섹터 전체의 투자 심리가 살아있다는 증거이기도 해요.
최근 뉴스에 따르면 에임드바이오는 상장 직후부터 '다크호스'로 불리며 주목받았고, 12월 들어 변동성이 커지긴 했지만, 우상향 추세를 만들어가고 있어요.



단순 기대감을 넘어 실체를 볼 때
제 개인적인 생각으로는, 에임드바이오의 현재 주가 급등은 단순한 '거품'으로만 보기는 어려워요.
전 세계적으로 글로벌 빅파마들이 ADC 기술을 확보하기 위해 혈안이 되어 있거든요.
이런 상황에서 환자 데이터를 기반으로 임상 성공률을 높일 수 있는 에임드바이오의 플랫폼 기술은 충분히 매력적인 매물일 수 있어요.
다만, 주의해야 할 점은 변동성이에요.
실적이 뒷받침되지 않는 바이오 주식은 기대감만으로 오르기 때문에, 임상 데이터 발표나 기술 수출 공시가 지연되면 주가가 급락할 위험도 언제나 도사리고 있거든요.
따라서 이 종목에 접근하실 때는 '단기 차익'을 노리는 트레이딩 관점보다는, 회사의 기술력이 실제로 글로벌 계약으로 이어지는지 뉴스를 꼼꼼히 챙기며 대응하는 것이 중요해요.
특히 외국인과 기관의 수급이 지속해서 들어오는지는 반드시 매일 체크해야 할 포인트랍니다.
지금의 상승세가 꺾이지 않는다면, 2025년 연말 바이오 주도주로서의 입지를 굳힐 가능성도 충분해 보여요.
결론
에임드바이오는 ADC라는 강력한 무기와 환자 유래 모델이라는 차별성을 가진, 2025년 코스닥 시장의 핵심 유망주예요.
당장의 재무적 성과보다는 기술 이전 가능성과 임상 데이터의 가치에 주목해야 하는 시점이고요.
높은 변동성을 감내할 수 있는 투자자라면, 바이오 섹터의 훈풍과 함께 회사의 성장 스토리를 지켜보는 것도 흥미로운 투자가 될 수 있을 거예요.